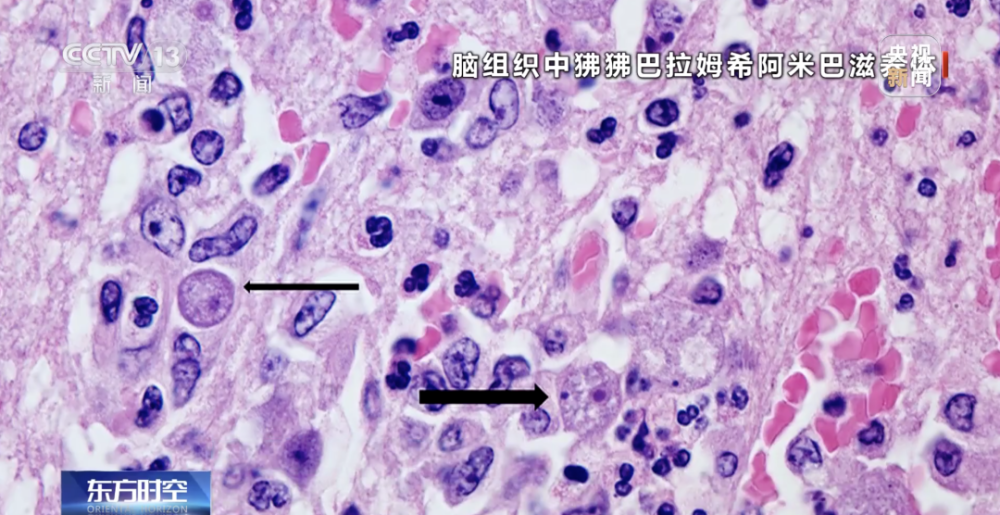

6歲童和朋友「打水仗竟去世」!送醫檢查出「致死率98%恐怖疾病」

今年7月,男童打水仗後發燒感染狒狒阿米巴原蟲(食腦蟲)引發廣泛關注。
據現代快報報道,8月11日晚,孩子媽媽在社群平台發布了一封「君寶貝和媽媽的感謝信」,感謝信中,稱孩子:「生命留在6歲8個月」,結尾稱「也請大家給我們點時間,處理完剩下的事情,感謝。感恩所有幫助過我們的朋友們。」評論區網友紛紛留言「節哀」。
8月12日,記者聯繫孩子媽媽,截至發稿前並未得到回復。

今年6月,孩子媽媽在社群平台發文,稱孩子在上海復旦大學附屬醫院通過腰穿腦積液的檢查,檢查出來狒狒阿米巴原蟲。
對於為什麼感染,男童媽媽表示,目前想到的就只有6月6日在學校打水仗和4月13日在公園裡撈魚,沒有去過別的地方。

7月2日有關專家進行會診,會診結果將使用國產的硝羥喹啉進行治療,並且在走倫理用藥流程,目前不知道什麼時候能審批通過。7月3日,現代快報記者聯繫孩子媽媽了解到,目前已與製藥公司聯繫上,「我們自己看到網友評論,聯繫到了之前治癒的孩子爸爸,他推薦了相關製藥公司。我們醫生立馬聯繫了,現在就是在走流程。」孩子媽媽說。隨後,在醫院、藥廠、熱心網友的幫助下,孩子嘗試用了各類藥物和治療。
8月7日,孩子媽媽發文稱患兒已在PICU27天。
記者了解到,狒狒巴拉姆希阿米巴導致的中樞神經系統感染病情十分兇險,病死率高達98%。目前還沒有明確有效的治療方法。
「食腦蟲」並非昆蟲,藏身淡水與土壤
感染「食腦蟲」 病死率極高
「食腦蟲」並不是真的蟲子,而是一類分佈於自然界中的單細胞生物阿米巴原蟲。
首都醫科大學附屬北京友誼醫院、北京熱帶醫學研究所主任醫師王磊介紹,目前,稱之為「食腦蟲」的阿米巴原蟲有三種:福氏耐格里屬阿米巴、狒狒巴拉姆希阿米巴、雙核勻變蟲。
王磊表示,這三種阿米巴原蟲對人體造成損害主要有兩方面:











